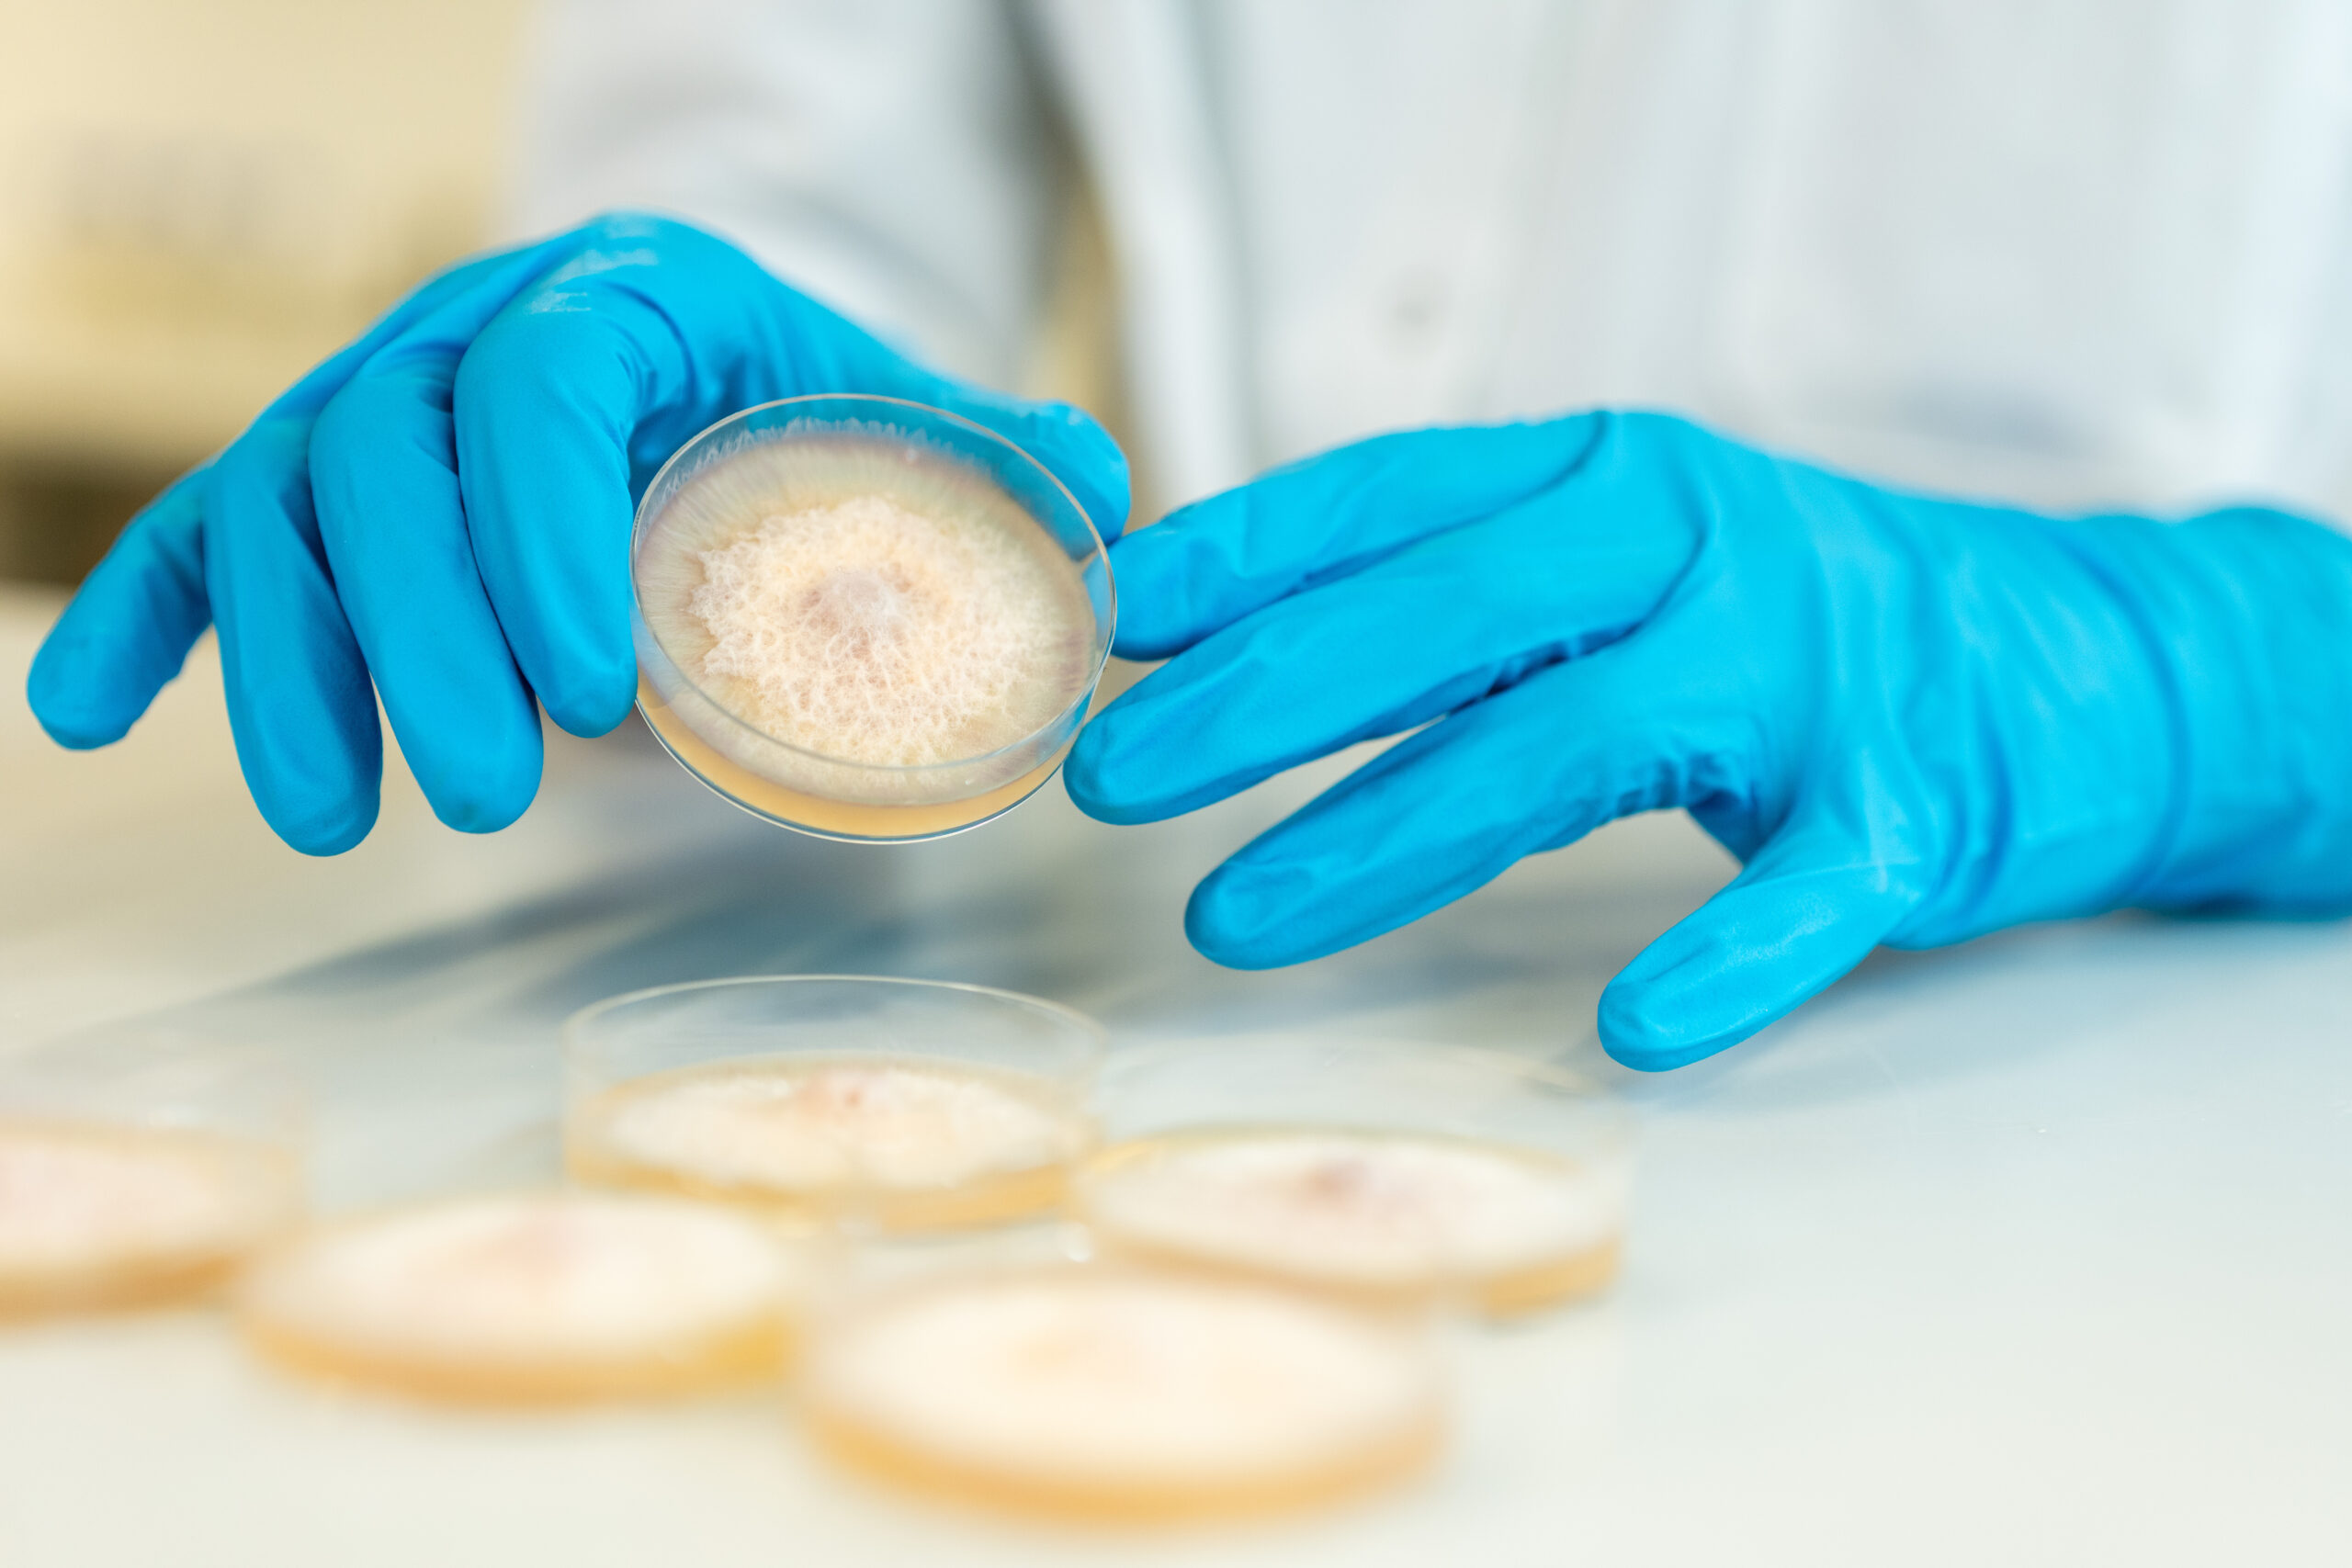

Kwizda Agro, einer der führenden Anbieter von chemischen und biologischen Pflanzenschutzlösungen in Österreich, übernimmt die Formulierung und Produktentwicklung zweier neuartiger mikrobieller Biostimulanzien des britischen Biotech-Unternehmens FA Bio. Die Kooperation verbindet FA Bios wissenschaftliche Entdeckungskraft mit der industriellen Entwicklungs- und Formulierungsstärke von Kwizda Agro. Ziel ist es, die pilzbasierten Wirkstoffe, die in Feldversuchen in Mais und Weizen Ertragssteigerungen von bis zu 25 Prozent erzielten, in stabile, marktfähige und praxistaugliche Produkte zu überführen.
„Die Formulierung ist der entscheidende Schritt, damit biologische Wirkstoffe ihr volles Potenzial entfalten können“, erklärt Kwizda Agro Geschäftsführer Ronald Hamedl. „Wir verfügen über jahrzehntelange Erfahrung in der Entwicklung mikrobieller und biologischer Produkte und genau diese Kompetenz bringen wir ein, um die FA-Bio-Innovationen rasch und zuverlässig zur Marktreife zu bringen.“
Formulierungskompetenz als Brücke
Biologische Wirkstoffe wie Mikroben oder Pilze reagieren empfindlich auf Umweltbedingungen wie Temperatur, Feuchtigkeit oder UV-Strahlung. Damit sie in der Praxis zuverlässig wirken, sind präzise abgestimmte Formulierungstechnologien notwendig. Kwizda Agro verfügt über ein internationales Entwicklungsnetzwerk und modernste Technologiezentren in Österreich, die auf die Stabilisierung und Skalierung biologischer Produkte spezialisiert sind. Im Rahmen der Kooperation mit FA Bio entwickelt Kwizda Agro:
- stabile Formulierungen, die die Lebensfähigkeit der Mikroorganismen sichern,
- innovative Träger- und Kapseltechnologien, die Wirkstoffe gezielt im Boden freisetzen,
- sowie skalierbare Produktionsprozesse, die eine industrielle Umsetzung ermöglichen.
„Unsere Aufgabe ist es, Entdeckungen aus der Mikrobiologie so zu übersetzen, dass sie als verlässliche Lösungen auf den Feldern ankommen“, so Hamedl. „Darin liegt unsere Kernkompetenz – die Verbindung von Forschung, Technologie und landwirtschaftlicher Anwendung.“
Von der Entdeckung zur Anwendung
FA Bio nutzt mit der patentierten SporSenZ™ Microbial Discovery Platform ein innovatives Verfahren, um Mikroorganismen direkt im Wurzelraum landwirtschaftlicher Kulturen zu erfassen. Diese Technologie steigert die Entdeckungsrate nützlicher Mikroben bis zu 6.000-fach im Vergleich zu klassischen Laborverfahren. „Kwizda Agro ist der ideale Partner, um unsere mikrobiellen Entdeckungen in marktreife Produkte zu überführen“, betont Natalia Taketani Franco, Head of Scientific Operations bei FA Bio. „Die Kombination aus Formulierungs-Know-how, technischer Infrastruktur und Marktverständnis ist entscheidend, um biologische Innovationen effizient und sicher in die Praxis zu bringen.“
Nachhaltige Entwicklung als strategisches Ziel
Mit der Kooperation stärkt Kwizda Agro seine Position als internationaler Entwicklungspartner biologischer Pflanzenschutz- und Biostimulanzlösungen. Das Unternehmen setzt gezielt auf Partnerschaften mit internationalen Forschungs- und Biotechunternehmen, um die Transformation zu nachhaltigen, naturbasierten Wirkstoffen voranzutreiben. „Unsere Vision ist klar: Wir wollen Landwirten leistungsstarke biologische Produkte bieten, die Produktivität und Nachhaltigkeit vereinen“, so Hamedl. „Mit FA Bio zeigen wir, wie technologische Exzellenz und Anwendungskompetenz zusammenwirken, um biobasierte Innovationen marktreif zu machen.“
Über Kwizda Agro
Kwizda Agro ist einer der führenden Anbieter von chemischen und biologischen Pflanzenschutzlösungen in Österreich und Teil der Kwizda Unternehmensgruppe. Mit nahezu 100 Jahren Erfahrung entwickelt das Unternehmen innovative Wirkstoffe und produziert komplexe, hochwertige Formulierungen am Standort Leobendorf. Bei der Entwicklung eigener Produkte liegt heute der Fokus auf rein biologischen Pflanzenschutzmitteln – ein klares Bekenntnis zur Nachhaltigkeit, das in der Unternehmensstrategie fest verankert ist und an den Standorten Leobendorf und Tulln konsequent vorangetrieben wird. Rund 480 Mitarbeiterinnen und Mitarbeiter arbeiten für Kwizda Agro in Österreich, Deutschland, Italien, Spanien, Ungarn, Rumänien und den USA. Über ein internationales Netzwerk unterstützt das Unternehmen Pflanzenschutzanwender mit digitalen, datenbasierten Services bei einem standortgerechten und nachhaltigen Pflanzenschutz. So leistet Kwizda Agro einen wesentlichen Beitrag zu vitalen Kulturen in der Landwirtschaft sowie zu gesunden Gärten als Orte der Erholung.